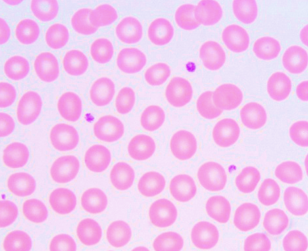

Ms. Sean peripheral smear showed this field below. If this field appears similar in 5 fields. What could be her estimated platelet count? *
12,000/uL
60,000/uL
100,000/uL
300,000/uL

60,000/uL
Transfusion of 1 unit of platelet concentrate containing approximately 0.7 X 1011 platelets should cause this platelet count increase in your patient: *
5000 to 10,000/ μl
7,000-12,000/ μl
10,000-15,000/μl
5000 to 10,000/ μl
Bleeding time is a screening test for the following EXCEPT: *
Sufficiency of platelets number (indirectly)
Speed on small cutaneous blood vessel constriction to control bleeding
Disorders of platelet function, both congenital and acquired
Monitoring tests on patients who had been on heparin therapy
Monitoring tests on patients who had been on heparin therapy
How many platelets do you expect to see per 100X field (OIF). in the blood smear if your patient is thrombocytopenic? *
below 8 platelets
below 15 platelets
below 25 platelets
below 8 platelets
When is the ideal time a Physician should be requesting for the blood smears of a patient suspected for Malaria? *
after exposure to the vector mosquito
first day of afebrile state
at height of fever
just prior to the next anticipated fever spike
just prior to the next anticipated fever spike
Estimate this patient’s blood platelet count: *
need more data
normal
thrombocytopenia
thrombocytosis
thrombocytopenia
If each unit of random platelet concentrate could increase platelet count by 5000 to 10,000 / μl, how many units of Platelet Concentrate will you order to bring Ms. Sean’s count to normal? *
None is needed
5 bags
9 bags
26 bags

9 bags
Complications of Deep venipuncture in infants EXCEPT: *
venous constriction followed by gangrene
Syncope
damage to organs or tissues accidentally punctured
cardiac arrest
Syncope
A 40 y.o. patient was rushed to the emergency room fur to difficulty of breathing. Chest X-ray show bilateral pleural effusion. Thoracentesis was done which revealed whitish, cloudy fluid. Which of the following findings will confirm a Chylothorax condition? *
triglycerides values 2.0mmol/l; cholesterol 5mmol/L
triglycerides values 2.3mmol/l; cholesterol 7mmol/L
triglycerides values 1.2 mmol/l; cholesterol 5.5mmol/L
triglycerides values 1.0mmol/l; cholesterol 6.8mmol/L
triglycerides values 2.0mmol/l; cholesterol 5mmol/L
***Triglycerides values 1.0 mmol/1; cholesterol 6.8 mmol/L
NORMAL VALUES *
Normal bleeding time
1-3minutes
3 to 6 minutes
1-3minutes
NORMAL VALUES *
Normal clotting time
1-3minutes
3 to 6 minutes
3 to 6 minutes
Identify the layer referred to: *
Serum
A
B
C
All
None

None
Identify the layer referred to: *
increased in volume in Polycythemic patient
A
B
C
All
None

None/C???
Identify the layer referred to: *
affected in hypovolemia
A
B
C
All
None

All
Identify the layer referred to: *
decreases in dehydration
A
B
C
All
None

C
Identify the layer referred to: *
decreases in anemia
A
B
C
All
None

C
Identify the layer referred to: *
increases in leukocytic leukemia
A
B
C
All
None

B
STANDING PLASMA TEST: *
c
1
11a
11b
111
1V
V

11b
STANDING PLASMA TEST: *
D
1
11a
11b
111
1V
V

V
STANDING PLASMA TEST: *
B
1
11a
11b
111
1V
V

11a
STANDING PLASMA TEST: *
A
1
11a
11b
111
1V
V

1
FACTORS affecting Bleeding & Clotting Time: *
Hemophilia
Increased Clotting Time
Increased Bleeding Time
Both
Both
FACTORS affecting Bleeding & Clotting Time: *
von Willebrand’s disease
Increased Clotting Time
Increased Bleeding Time
Both
Both
FACTORS affecting Bleeding & Clotting Time: *
factor XI deficiency
Increased Clotting Time
Increased Bleeding Time
Both
Both





